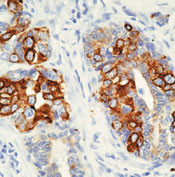
Cytokeratin 8 Antibody in Immunohistochemistry (Paraffin) (IHC (P))

Search
Invitrogen
Cytokeratin 8 Monoclonal Antibody (TS1), Biotin
{{$productOrderCtrl.translations['antibody.pdp.commerceCard.promotion.promotions']}}
{{$productOrderCtrl.translations['antibody.pdp.commerceCard.promotion.viewpromo']}}
{{$productOrderCtrl.translations['antibody.pdp.commerceCard.promotion.promocode']}}: {{promo.promoCode}} {{promo.promoTitle}} {{promo.promoDescription}}. {{$productOrderCtrl.translations['antibody.pdp.commerceCard.promotion.learnmore']}}
产品信息
MA5-14425
种属反应
已发表种属
宿主/亚型
分类
类型
克隆号
抗原
偶联物
形式
浓度
规格
纯化类型
保存液
内含物
保存条件
运输条件
RRID
产品详细信息
MA5-14425 targets Cytokeratin 8 in IHC (P) and IP applications and shows reactivity with Human samples.
The MA5-14425 immunogen is keratin preparation from a human carcinoma.
靶标信息
Cytokeratin 8 is a member of the type II keratin family clustered on the long arm of chromosome 12. Type I and type II keratins heteropolymerize to form intermediate-sized filaments in the cytoplasm of epithelial cells. Cutokeratin 8 typically dimerizes with keratin 18 to form an intermediate filament in simple single-layered epithelial cells. This protein plays a role in maintaining cellular structural integrity and also functions in signal transduction and cellular differentiation. Mutations in this gene cause cryptogenic cirrhosis.
仅用于科研。不用于诊断过程。未经明确授权不得转售。
生物信息学
蛋白别名: CK-8; cytokeratin 8; Cytokeratin-8; K8; keratin 8, type II; Keratin, type II cytoskeletal 8; Keratin-8; Type-II keratin Kb8; unnamed protein product
基因别名: CARD2; CK-8; CK8; CYK8; K2C8; K8; KO; KRT8
UniProt ID: (Human) P05787
Entrez Gene ID: (Human) 3856